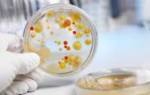

Зачем необходимо железо в организме?
Железо — важный химический элемент, выполняющий ключевые функции в организме. Поскольку организм не производит железо, его необходимо получать из пищи. Рацион должен быть сбалансированным и включать все необходимые витамины и минералы. Недостаток или избыток этих веществ может привести к заболеваниям и ухудшению здоровья.
Железо в организме делится на:
- Функциональное железо. Часть гемоглобина (белка эритроцитов для транспортировки кислорода), миоглобина (белка для хранения кислорода в мышцах) и ферментов. Оно активно участвует в различных процессах.
- Транспортное железо. Перемещается от источника поступления до клеток, не участвует в биохимических процессах и входит в состав белков-переносчиков, таких как трансферрин, лактоферрин и мобилферрин.
- Депонированное железо. Откладывается «про запас» в печени и селезенке в виде ферритина или гемосидерина.
- Свободное железо. Несвязанное с белками, образуется при выходе из комплекса с апотрансферрином и рецептором. В свободном состоянии токсично, поэтому транспортируется мобилферрином или депонируется с ферритином.
По локализации в организме выделяют:
- Гемовое железо (клеточное). Составляет 70-75% общего содержания железа, участвует в обмене ионов и входит в состав гемоглобина, миоглобина и ферментов.
- Негемовое железо. Делится на внеклеточное и депонированное. Внеклеточное включает свободное железо в плазме и транспортные белки. Депонированное представлено ферритином и гемосидерином.
Основные функции железа:
- Транспорт кислорода к тканям. Гемоглобин в эритроцитах связывает и переносит кислород от легких к клеткам.
- Участие в кроветворении. Костный мозг использует железо для синтеза гемоглобина.
- Дезинтоксикация. Железо необходимо для синтеза ферментов печени, разрушающих токсины.
- Регуляция иммунитета. Влияет на состав крови и уровень лейкоцитов.
- Участие в делении клеток. Входит в состав белков и ферментов, участвующих в синтезе ДНК.
- Синтез гормонов. Необходимо для производства гормонов щитовидной железы.
- Обеспечение клеток энергией. Транспортирует кислород в молекулы, участвующие в энергетических процессах.
Железо поступает в организм с пищей: красное мясо, темное мясо птицы, сушеные грибы, бобовые, овощи, фрукты и какао. Суточная потребность варьируется от 6 до 40 миллиграммов. Токсическая доза составляет 150-200 мг, летальная — 7-35 г.
Суточная потребность в железе
| Пол | Возраст | Суточная потребность железа |
| Дети(независимо от пола) | 1 – 3 года | 6,8 мг в сутки |
| 3 – 11 лет | 10 мг в сутки | |
| 11 – 14 лет | 12 мг в сутки | |
| Женщины | 14 – 18 лет | 15 мг в сутки |
| 19 – 50 лет | 18 мг в сутки | |
| старше 50 лет | 8 мг в сутки | |
| Беременные женщины | — | 38 мг в сутки |
| Кормящие женщины | — | 33 мг в сутки |
| Мужчины | 14 – 18 лет | 11 мг в сутки |
| старше 19 лет | 8 мг в сутки |
Железо распределяется в организме в зависимости от типа и пола.
Распределение железа в организме человека
| Тип железа | Концентрация железа (мг Fe/кг) | |
| женщины | мужчины | |
| Общее количество железа | ||
| Общее содержание железа составляет 4,5 – 5 граммов. | 40 мг Fe/кг | 50 мг Fe/кг |
| Функциональное железо | ||
| Гемоглобин (Hb). 75 – 80% от общего количества (2,4 г) составляет гемоглобиновое железо. | 28 мг Fe/кг | 31 мг Fe/кг |
| Миоглобин. 5 – 10% от общего количества. | 4 мг Fe/кг | 5 мг Fe/кг |
| Гемовые и негемовые ферменты. Около 1% от общего количества. | 1 мг Fe/кг | 1 мг Fe/кг |
| Транспортное железо | ||
| Трансферрин. | < 1 (0,2) мг Fe/кг | < 1 (0,2) мг Fe/кг |
| Депо железа. Резервное железо составляет 20 – 25% от общего количества. | ||
| Ферритин. | 4 мг Fe/кг | 8 мг Fe/кг |
| Гемосидерин. | 2 мг Fe/кг | 4 мг Fe/кг |
Сывороточное железо является важным показателем состояния организма, отражающим уровень железа в крови. Врачи отмечают, что нормальные значения сывороточного железа варьируются в зависимости от возраста и пола, но в среднем составляют от 10 до 30 мкмоль/л. Изменение этих показателей может свидетельствовать о различных состояниях. Например, пониженное содержание железа часто указывает на анемию, нехватку железа или хронические заболевания. В то же время повышенные уровни могут быть связаны с перегрузкой железом, воспалительными процессами или заболеваниями печени. Важно учитывать, что для точной диагностики необходимо проводить комплексное обследование, включая анализы на ферритин и трансферрин, что поможет врачам определить причину изменений и назначить соответствующее лечение.

Обмен железа в организме человека
Метаболизм железа в организме — это организованный процесс, регулирующий поступление и переработку этого микроэлемента с высокой точностью.
Всасывание железа делится на три этапа: первый — всасывание в тонком кишечнике, второй — внутриклеточный транспорт и накопление запасов, третий — высвобождение в кровяную плазму.
Железо поступает с пищей. При потреблении 10-20 мг железа усваивается лишь 10%, то есть 1-2 мг. Организм получает как гемовое (из мяса и печени), так и негемовое железо (из молока, овощей и фруктов). Гемовое железо усваивается на 20-30% эффективнее, независимо от секреции желудочного сока. Негемовое железо, составляющее 80-90% потребляемого, усваивается пассивно и в меньших количествах (1-7%), на что влияют внешние факторы.
Вещества, снижающие усвоение негемового железа:
- фитины — в злаках, бобовых, манной и овсяной кашах;
- танины — в чае, какао, кофе, айве, темном винограде, смородине;
- фосфопротеины — в молоке и яичном белке;
- оксалаты — в кукурузе, рисе, шпинате, молоке;
- некоторые медикаменты — препараты кальция, оральные контрацептивы.
Увеличение усвоения железа происходит при употреблении:
- витамина С — в белокочанной капусте, шпинате, перце, черной смородине, сушеном шиповнике;
- меди — в печени, арахисе, фундуке, креветках, горохе, гречке, чечевице;
- мясных продуктах — говядине, телятине, крольчатины;
- морепродуктах — рыбе, устрицах, креветках;
- аминокислотах — в бобовых, орехах, рыбе, мясе, молоке, яйцах.
В пище железо в основном находится в окисленном состоянии (Fe3+) и входит в состав белков и органических кислот. Однако двухвалентное железо (Fe2+) усваивается эффективнее. В желудке под воздействием желудочного сока трехвалентное железо (Fe3+) преобразуется в двухвалентное (Fe2+), что ускоряется аскорбиновой кислотой и ионами меди. Основное усвоение происходит в тонком кишечнике — до 90% в двенадцатиперстной и начальных отделах тощей кишки. Заболевания желудка и кишечника могут нарушать усвоение железа.
После поступления двухвалентного железа (Fe2+) в тонкий кишечник оно попадает в энтероциты (эпителиальные клетки). Усвоение осуществляется с помощью белков — мобилферрина, интегрина и других. В клетках находятся трансферрин и ферритин, регулирующие усвоение и распределение железа.
Часть железа откладывается, а часть транспортируется трансферрином для синтеза гема и эритропоэза. Депонирование происходит в двух формах — ферритина и гемосидерина. Ферритин — водорастворимый белковый комплекс, синтезируемый клетками печени, костного мозга, тонкого кишечника и селезенки, связывает и хранит железо. Гемосидерин — водонерастворимый пигмент, накапливающий избыток железа в тканях.
Транспортировка железа в плазме крови осуществляется трансферрином, синтезируемым клетками печени. Он транспортирует усвоенное железо и железо из разрушенных эритроцитов. В норме трансферрин насыщается железом лишь на 33%.
Организм ежедневно теряет железо — до 1-2 мг. Физиологические потери происходят через желчь, отшелушивание эпителия ЖКТ, десквамацию кожи, менструальную кровь (от 14 до 140 мг в месяц), выпадение волос и срезание ногтей.
| Показатель | Нормальные значения (мкмоль/л) | Возможные причины отклонения от нормы |
|---|---|---|
| Сывороточное железо | Мужчины: 11-31; Женщины: 8-30 | Понижение: Железодефицитная анемия, хронические заболевания, беременность, кровопотеря, недостаточное потребление железа, нарушение всасывания железа. Повышение: Гемосидероз, гемохроматоз, передозировка железа, разрушение эритроцитов. |
| Общее количество железа в сыворотке | Мужчины: 40-150 мкг/дл; Женщины: 30-140 мкг/дл | Понижение: Аналогично сывороточному железу. Повышение: Аналогично сывороточному железу. |
| Ферритин | Мужчины: 30-400 нг/мл; Женщины: 10-120 нг/мл | Понижение: Железодефицитная анемия, воспаление, недостаточное потребление железа. Повышение: Гемохроматоз, гемосидероз, воспаление, заболевания печени, ожирение. |
| Трансферрин | 200-400 мг/дл | Понижение: Заболевания печени, нефротический синдром, недостаток белка. Повышение: Железодефицитная анемия, беременность. |
| Процент насыщения трансферрина | 16-50% | Понижение: Железодефицитная анемия. Повышение: Гемохроматоз, гемосидероз. |
Что такое сывороточное железо и какова норма железа в крови? Для чего проводят анализ сывороточного железа?
Сывороточное или плазменное железо — это уровень железа в сыворотке или плазме крови, исключая железо в гемоглобине и ферритине. Плазма — жидкая часть крови, составляющая около 60% от общего объема, светло-желтого цвета и не содержащая форменных элементов (эритроцитов, тромбоцитов, лейкоцитов и лимфоцитов). Она состоит из воды и растворенных белков, газов, минералов, жиров и других веществ. Сыворотка крови — это плазма без фибриногена, белка, участвующего в образовании тромба.
Железо в крови не может находиться в свободном виде из-за токсичности. Уровень железа определяется в белках-переносчиках, таких как трансферрин. Для анализа железо выделяется из комплекса с трансферрином. Исследование проводится на венозной крови, наиболее распространенный метод — колориметрический, основанный на определении уровня железа по интенсивности окраски раствора, что обеспечивает высокую точность измерений.
Показаниями для анализа уровня сывороточного железа являются:
- диагностика анемий с низким содержанием гемоглобина;
- диагностика гемохроматоза, наследственного заболевания с нарушением обмена железа;
- выявление интоксикации железом;
- недостаточное питание и гиповитаминозы;
- заболевания желудочно-кишечного тракта, влияющие на всасывание железа;
- отклонения в общем анализе крови (изменения в количестве эритроцитов и гематокрита);
- кровотечения различного происхождения (обильные менструации, кровоточивость десен, язвы).
Анализ на сывороточное железо проводится для:
- оценки запасов железа в организме;
- расчета процента насыщения трансферрина железом;
- дифференциальной диагностики анемий;
- контроля лечения анемий и препаратами железа;
- диагностики генетических заболеваний, связанных с обменом железа.
Нормальные значения железа в крови зависят от возраста и пола:
| Возраст | Пол | Норма железа |
| < 1 месяца | женский | 5,1 – 22,6 мкмоль/л |
| мужской | 5,6 – 19,9 мкмоль/л | |
| от 1 до 12 месяцев | женский | 4,6 – 22,5 мкмоль/л |
| мужской | 4,9 – 19,6 мкмоль/л | |
| от 1 до 4 лет | женский | 4,6 – 18,2 мкмоль/л |
| мужской | 5,1 – 16,2 мкмоль/л | |
| от 4 до 7 лет | женский | 5,0 – 16,8 мкмоль/л |
| мужской | 4,6 – 20,5 мкмоль/л | |
| от 7 до 10 лет | женский | 5,5 – 18,7 мкмоль/л |
| мужской | 4,9 – 17,3 мкмоль/л | |
| от 10 до 13 лет | женский | 5,8 – 18,7 мкмоль/л |
| мужской | 5,0 – 20,0 мкмоль/л | |
| от 13 до 16 лет | женский | 5,5 – 19,5 мкмоль/л |
| мужской | 4,8 – 19,8 мкмоль/л | |
| от 16 до 18 лет | женский | 5,8 – 18,3 мкмоль/л |
| мужской | 4,9 – 24,8 мкмоль/л | |
| > 18 лет | женский | 8,9 – 30,4 мкмоль/л |
| мужской | 11,6 – 30,4 мкмоль/л |
При анализе результатов врач учитывает пол и возраст пациента. Низкий уровень железа указывает на дефицит, высокий — на избыток. Важно учитывать факторы, такие как питание, медикаменты, менструальный цикл и суточные колебания уровня железа. Максимальная концентрация наблюдается утром, а у женщин перед и во время менструации уровень железа выше. Рекомендуется сдавать анализ после окончания менструации. Также возможны случайные изменения уровня железа при увеличении потребления мяса.
Лекарственные препараты, повышающие уровень железа в крови:
- ацетилсалициловая кислота (аспирин) — нестероидное противовоспалительное средство;
- метотрексат — противоопухолевый препарат;
- мультивитамины с содержанием железа;
- оральные контрацептивы — противозачаточные таблетки;
- антибиотики — метициллин, хлорамфеникол, цефотаксим;
- препараты с эстрогенами — женские половые гормоны.
Лекарственные средства, снижающие уровень железа в крови:
- ацетилсалициловая кислота в больших дозах — нестероидное противовоспалительное средство;
- аллопуринол — препарат, снижающий уровень мочевой кислоты;
- кортизол — глюкокортикоидный гормон;
- метформин — гипогликемическое средство;
- кортикотропин — адренокортикотропный гормон;
- холестирамин — гиполипидемическое средство;
- аспарагиназа — противоопухолевый препарат;
- препараты с тестостероном — мужской половой гормон.
Для точных результатов анализа уровня железа в крови необходима правильная подготовка пациента к исследованию.
Сывороточное железо — важный показатель, который помогает оценить уровень железа в организме и его запасы. Нормальные значения варьируются в зависимости от возраста и пола, но в среднем составляют от 11 до 30 мкмоль/л. Изменение показателей может сигнализировать о различных состояниях. Например, низкий уровень сывороточного железа часто указывает на анемию, недостаток железа или хронические заболевания. В то же время повышенные значения могут свидетельствовать о перегрузке железом, что бывает при гемохроматозе или хронических воспалительных процессах. Люди часто отмечают, что регулярный контроль уровня железа помогает предотвратить серьезные проблемы со здоровьем и поддерживать общее самочувствие. Важно помнить, что интерпретацию результатов должен проводить врач, учитывая индивидуальные особенности пациента.

Как правильно подготовиться к сдаче анализа на сывороточное железо?
Для точного анализа концентрации железа в сыворотке крови необходимо правильно подготовить пациента.
Подготовка к исследованию уровня железа в крови:
- За неделю до анализа прекратить прием медикаментов и витаминов с железом.
- Отложить анализ на несколько дней после гемотрансфузии.
- Объяснить пациенту процесс взятия образца крови и возможные неприятные ощущения при наложении жгута и пункции вены.
- Описать режим питания и дня, который пациент должен соблюдать.
Требования к проведению анализа крови на сывороточное железо:
- Сдача крови натощак.
- Исключение курения, алкоголя, жирной пищи и физической активности за 12 часов до анализа.
- Взятие образца крови до любых диагностических процедур.
- Отсутствие у пациента вирусных и воспалительных заболеваний.

Каким должен быть уровень сывороточного железа при беременности?
Беременность — это важный и сложный этап в жизни женщины, сопровождающийся серьезными физиологическими изменениями. Плод использует микро- и макроэлементы матери как «строительные блоки», поэтому важно, чтобы питание было сбалансированным и обеспечивало достаточное количество витаминов, минералов и белков. Потребность в этих элементах во время беременности превышает норму для небеременной женщины, так как они необходимы как для матери, так и для плода.
Основные причины увеличения потребности в железе во время беременности:
- Увеличение объема крови на 50%, что требует двукратного роста потребности в железе для синтеза гемоглобина (белка, содержащего железо, который переносит кислород);
- Использование железа из запасов матери для формирования плаценты и эритроцитов (красных кровяных клеток, которые переносят кислород) плода;
- Наличие железодефицитной анемии (состояния с пониженным уровнем гемоглобина) до беременности, что усугубляет дефицит железа.
У беременных женщин увеличивается ежедневное потребление железа. В первом триместре дополнительные затраты составляют 0,8 миллиграммов в сутки, во втором — 4–5 миллиграммов, а в третьем — до 6,5 миллиграммов. Для развития плода требуется 400 миллиграммов железа, на увеличившуюся матку — 50–75 миллиграммов, а для формирования плаценты — 100 миллиграммов. В целом для нормального течения беременности и родов женщине необходимо около 800 миллиграммов железа дополнительно. Во время беременности и родов (при отсутствии осложнений) расходуется около 650 миллиграммов железа.
Нормальный уровень сывороточного железа у беременных составляет от 13 до 30 мкмоль/л. Суточная потребность в железе для беременных достигает 30–38 миллиграммов.
Недостаток и избыток железа одинаково опасны для беременной и ее ребенка. При недостатке железа запасы быстро истощаются, что может привести к дефициту (уровень сывороточного железа < 13 мкмоль/л) и железодефицитной анемии. Это состояние вызывает недостаток кислорода как у матери, так и у плода, ослабляет иммунную систему, вызывает утомляемость, головокружение и слабость. Анемия в первом или втором триместре увеличивает риск преждевременных родов, низкого веса ребенка, мертворождения или смерти новорожденного.
Дефицит железа у матери может привести к анемии у новорожденного, что негативно скажется на его развитии. Во время родов женщина может потерять много крови, и если до этого был дефицит, это может привести к тяжелой анемии и необходимости переливания крови. Нехватка железа также связана с послеродовой депрессией.
Избыток железа (уровень сывороточного железа > 30 мкмоль/л) также негативно сказывается на беременности и здоровье плода. Он может возникнуть при наследственных заболеваниях или чрезмерном поступлении железа (неконтролируемый прием препаратов). Чрезмерное содержание железа может привести к гестационному диабету (повышенный уровень сахара в крови), преэклампсии (осложнение беременности с высоким давлением и белком в моче) и выкидышу. Поэтому прием препаратов железа должен контролироваться врачом.
Дефицит железа у беременных встречается чаще, чем избыток. Его можно восполнить диетой, богатой железом, или препаратами. В рационе должны быть красное мясо (наиболее богатый источник железа), мясо кролика, курицы, индейки, а также зерновые, бобовые, шпинат, капуста и каши.
Если поступление железа с пищей недостаточно, врач может назначить препараты. Прием таких препаратов контролируется по уровню сывороточного железа. Дозировку назначает врач, исходя из лабораторных показателей (уровень сывороточного железа, гемоглобина). Часто беременным назначают препараты кальция, которые могут ухудшать усвоение железа. Поэтому в период лечения препаратами железа рекомендуется ограничить прием кальция или принимать его в перерывах между приемом пищи и препаратов.
Препараты железа, которые могут быть назначены во время беременности:
- Сорбифер дурулес. 100 миллиграммов железа и витамин С для улучшения усвоения. Для профилактики — 1 таблетка в день, для лечения — по 1 таблетке утром и вечером.
- Ферроплекс. Драже с 50 миллиграммами железа и витамином С. Рекомендуется по 2 драже 3 раза в день.
- Тотема. Раствор с 50 миллиграммами железа. Для профилактики — 1 ампула в день с 4 месяца беременности. В больших дозах — только при подтвержденной анемии, по 2–4 ампулы в сутки.
- Фенюльс. Капсулы с 45 миллиграммами железа. Для профилактики — 1 капсула в день с 14 недели беременности. После 2 недель приема — недельный перерыв, затем продолжают.
Побочные эффекты препаратов железа могут включать тошноту, боли в животе, запор или диарею. Стул может стать черным, что нормально. При появлении побочных эффектов необходимо обратиться к врачу для коррекции дозы или отмены препарата.
Какие заболевания приводят к снижению уровня железа крови?
Множество заболеваний, привычек и особенностей питания влияют на уровень железа в крови, снижая его концентрацию.
Факторы, способствующие снижению уровня железа в крови:
- Недостаток железа в рационе. Нехватка железа может возникнуть из-за несбалансированного питания или строгих диет, особенно у вегетарианцев, так как железо из мяса усваивается легче.
- Увеличение потребления железа. В период активного роста, беременности и грудного вскармливания организму требуется больше железа.
- Недостаток витаминов. Низкое потребление витаминов группы В и витамина С ухудшает усвоение железа, так как эти витамины способствуют его лучшему усвоению.
- Инфекционные заболевания. Острые и хронические инфекции, а также лихорадка снижают уровень железа в крови, так как организм уменьшает его доставку к тканям для замедления размножения бактерий.
- Проблемы с аппетитом. Дисгевзия и анорексия приводят к недостаточному поступлению железа и витаминов. Дисгевзия искажает или лишает вкусовых ощущений, а анорексия проявляется отсутствием аппетита и отказом от пищи.
- Заболевания ЖКТ. Патологии органов пищеварения, такие как атрофические гастриты и энтероколиты, нарушают всасывание железа в тонком кишечнике.
- Гельминтозы. Паразитарные инфекции, особенно у детей, могут вызывать дефицит железа, так как паразиты используют микроэлементы хозяина. Некоторые из них, такие как аскариды и анкилостомы, питаются кровью, что снижает уровень гемоглобина и железа.
- Беременность и лактация. В третьем триместре беременности потребность в железе у женщины возрастает. Недостаток железа может привести к серьезным осложнениям, так как новорожденный получает его через грудное молоко.
- Кровопотеря. При кровотечениях организм теряет железо из гемоглобина. Обильные менструации и другие источники кровопотери могут вызвать дефицит, особенно при хронических кровотечениях.
- Физическое и умственное напряжение. Интенсивная физическая или умственная активность требует больше железа, что может истощить запасы и ухудшить состояние.
- Климакс. В период климакса у женщин происходят изменения, негативно влияющие на обмен веществ и усвоение железа.
- Интоксикация. Железо необходимо для синтеза печеночных ферментов, разрушающих токсины. При отравлениях потребность в этих ферментах возрастает, увеличивая расход железа.
- Избыток веществ, препятствующих усвоению железа. Избыточное количество витамина Е, фосфатов, кальция, оксалатов и цинка замедляет усвоение железа. Например, беременным часто назначают кальций, поэтому важно периодически проверять уровень железа в сыворотке крови.
Симптомы дефицита железа в организме
Недостаток железа в организме может вызвать серьезные проблемы с функционированием органов, нехватку кислорода, а также нарушить синтез ферментов и гормонов. Симптомы дефицита железа не проявляются сразу: сначала организм использует запасы, и только после их истощения появляются признаки, которые со временем усиливаются.
Существует два типа признаков недостатка железа: латентные (скрытые) и явные. Латентные признаки возникают при небольшом дефиците. Уровень сывороточного железа может оставаться нормальным или близким к нижней границе нормы (для женщин – 8,9 мкмоль/л, для мужчин – 11,6 мкмоль/л), так как организм продолжает использовать свои запасы.
К симптомам латентной стадии дефицита железа относятся:
- снижение работоспособности;
- повышенная утомляемость;
- общее недомогание и слабость;
- учащенное сердцебиение (тахикардия);
- повышенная раздражительность;
- депрессивные состояния;
- головные боли и головокружение;
- трудности с глотанием;
- глоссит (воспаление языка);
- выпадение волос;
- ломкость ногтей;
- бледность кожи;
- ухудшение памяти, внимания и мыслительных процессов;
- частые респираторные инфекции;
- бессонница.
Когда запасы железа истощаются и его поступление становится недостаточным, симптомы усиливаются. Тяжелый дефицит железа может привести к различным заболеваниям и осложнениям.
Симптомы выраженного дефицита железа включают:
- снижение иммунитета – частые вирусные и респираторные заболевания;
- пониженная температура тела и зябкость – температура ниже 36,6°С, дискомфорт при низких температурах, постоянное ощущение холода в конечностях;
- ухудшение памяти и внимания – трудности с концентрацией, запоминанием информации, частая забывчивость;
- снижение работоспособности – постоянная усталость и ощущение разбитости даже после сна;
- нарушения в работе желудочно-кишечного тракта – снижение аппетита, трудности с глотанием, боли в животе, запоры, метеоризм, изжога;
- повышенная утомляемость и мышечная слабость – усталость даже после небольшой активности, слабость в мышцах как при нагрузках, так и в покое;
- неврологические расстройства – повышенная раздражительность, вспыльчивость, депрессивные состояния, плаксивость, мигрирующие боли (головные, в области сердца);
- задержка умственного и физического развития у детей – недостаток железа вызывает кислородное голодание, что негативно сказывается на центральной нервной системе и развитии сердечно-сосудистой системы;
- геофагия (извращение питания) – желание употреблять несъедобные предметы, такие как мел, земля или песок;
- сухость и бледность кожи и слизистых оболочек – кожа становится сухой, шелушится, появляются трещины и морщины, образуются ранки в уголках рта (хейлит), стоматит (воспаление слизистой рта);
- сухость и ломкость волос и ногтей – волосы теряют блеск и объем, становятся ломкими, ногти слоятся и легко ломаются;
- головокружение и обмороки – снижение уровня гемоглобина приводит к кислородному голоданию, что проявляется головокружением и кратковременной потерей сознания;
- одышка и учащенное сердцебиение – дефицит железа вызывает нехватку кислорода, что организм пытается компенсировать учащением дыхания и сердцебиения.
Как повысить уровень железа в крови?
Перед началом терапии дефицита железа необходимо выяснить и устранить причину его возникновения. Без решения проблемы потери железа лечение будет временным, что потребует повторных курсов.
Перед использованием препаратов с железом или изменением рациона нужно пройти обследование и сдать анализ на уровень сывороточного железа. Если подтвердится дефицит, врач разработает индивидуальную стратегию лечения, учитывая уровень железа, состояние здоровья пациента (например, беременность) и наличие сопутствующих заболеваний, которые могут увеличивать потери железа.
При незначительном дефиците достаточно изменить рацион, увеличив потребление продуктов, богатых железом. Важно также учитывать, что в некоторых случаях (например, при хронических кровотечениях, беременности, грудном вскармливании или интенсивном росте) поступление железа из пищи может быть недостаточным. В таких ситуациях терапию дополняют приемом железосодержащих препаратов.
При выраженном дефиците лечение обычно начинается с приема лекарств в капсулах, таблетках или драже. В тяжелых случаях препараты железа могут назначаться внутривенно под контролем врача.
Диета при дефиците железа
В организм человека с пищей поступает гемовое и негемовое железо. Гемовое железо из гемоглобина усваивается лучше, чем растительное. Основные источники гемового железа — мясные продукты, тогда как негемовое железо содержится в растительных.
Источники гемового железа
| Продукт(100 граммов) | Содержание железа в миллиграммах(мг) |
| говядина | 2,7 |
| свинина | 1,7 |
| индюшатина | 3,7 – 4,0 |
| курятина | 1,6 – 3,0 |
| телятина | 2,8 |
| печень свиная | 19,0 |
| печень телячья | 5,5 – 11,0 |
| почки говяжьи | 7,0 |
| морская рыба | 1,2 |
| сердце | 6,3 |
| скумбрия | 2,4 |
| треска | 0,7 |
| моллюски | 4,2 |
| мидии | 4,5 |
| устрицы | 4,1 |
Негемовое железо из растительных продуктов представлено в двухвалентной (Fe2+) и трехвалентной (Fe3+) формах, но усваивается хуже.
Источники негемового железа
| Продукт(100 граммов) | Содержание железа в миллиграммах(мг) |
| абрикосы | 2,2 – 4,8 |
| горох | 8,0 – 9,5 |
| бобы | 5,6 |
| гречка | 8,0 |
| орехи (миндаль, фундук) | 6,1 |
| сушеные грибы | 35 |
| сушеная груша | 13 |
| фасоль | 11,0 – 12,5 |
| яблоки | 0,6 – 2,3 |
| яблоки сушеные | 15,0 |
| шиповник | 11,0 |
Для оптимального усвоения железа рекомендуется:
- Включать в рацион продукты, богатые витамином С, витаминами группы В и фолиевой кислотой. Витамин С в шесть раз улучшает усвоение железа, поэтому стоит увеличить потребление шпината, цветной капусты, цитрусовых и брокколи. Фолиевая кислота содержится в арахисе, миндале, грецких орехах и семенах льна. Витамины группы В можно найти в кисломолочных продуктах, орехах, дрожжах и яичных желтках.
- Сократить потребление чая и кофе. Танин в этих напитках снижает усвоение железа. Не рекомендуется пить чай и кофе сразу после еды, так как они могут уменьшить всасывание железа на 62%. В норме организм усваивает лишь 10% железа из пищи.
- Ограничить употребление продуктов, богатых кальцием, и кальциевых добавок. Кальций препятствует усвоению железа, поэтому при лечении железодефицитных состояний стоит уменьшить потребление твердого сыра, молока, кунжута и зелени. Если пациент принимает кальциевые препараты, их следует отменить или сократить, а если это невозможно, принимать кальций между приемами пищи.
Препараты железа
Если диетические меры не повышают уровень сывороточного железа, врач может назначить препараты железа. Дозировка и продолжительность лечения определяются индивидуально. Терапия должна контролироваться по уровню сывороточного железа, который проверяется в лаборатории.
Препараты железа, применяемые при дефиците железа
| Препарат | Доза, длительность лечения |
| Мальтофер | Раствор для перорального применения. Для лечения дефицита железа — 1 флакон (100 мг железа) 1–3 раза в день. Курс — 3–5 месяцев, затем 1 флакон в день в течение 1–3 месяцев для восстановления запасов. Для профилактики — 1 флакон в день на 1–2 месяца. |
| Биофер | Для лечения — 1 таблетка (100 мг железа) 1–3 раза в день на 3–5 месяцев. Затем 1 таблетка в день для восстановления запасов. Для профилактики — 1 таблетка в день на 1–2 месяца. Содержит фолиевую кислоту для лучшего усвоения железа. |
| Ферро-фольгамма | Для лечения — 1 капсула (37 мг железа) 3 раза в день. Длительность — 3–16 недель в зависимости от дефицита. Для профилактики — 1 капсула 3 раза в день на месяц. Содержит витамин В12 и фолиевую кислоту. |
| Ферретаб | Применяют 1–3 капсулы (50 мг железа) в сутки. Лечение продолжается до нормализации уровня железа, затем поддерживающая терапия — 4 недели. Содержит фолиевую кислоту. |
| Гемофер | Принимается внутрь по 46 капель (2 мг железа в капле) 2 раза в день с соком или водой. Длительность — не менее 2 месяцев. |
| Сорбифер дурулес | Принимается по 1 таблетке (40 мг железа) 1–2 раза в день. Дозу можно увеличить до 3–4 таблеток в день. Курс — 3–4 месяца. Содержит аскорбиновую кислоту. |
| Тардиферон | Принимается по 1 таблетке (80 мг железа) 2 раза в день до еды или во время еды. Длительность — 3–6 месяцев. |
| Феррум | Инъекционная форма, вводится внутримышечно. Сначала тест-доза, затем полная доза. Назначается по 1–2 ампулы (100 мг железа) в сутки. |
| Венофер | Применяется только внутривенно. Вводится медленно после тест-дозы. Доза подбирается индивидуально. Одна ампула содержит 40 мг железа. |
| Космофер | Препарат для внутримышечного и внутривенного введения. Одна ампула — 100 мг железа. Доза и продолжительность лечения подбираются индивидуально. |
| Тотема | Раствор для перорального применения. В 1 ампуле — 50 мг железа. Назначается по 1 ампуле 2–3 раза в день, курс — до полугода. |
| Гематоген | В виде жевательных пастилок или плитки. Содержание железа варьируется. Рекомендуется по 1–2 пастилки 2–3 раза в день. |
Препараты железа назначаются внутривенно при тяжелых состояниях и заболеваниях ЖКТ, снижающих усвоение железа. Вводится тест-доза для исключения побочных эффектов, процедура проводится только в присутствии врача.
Для лечения и профилактики железодефицитных состояний у детей используются сиропы, плитки и жевательные пастилки.
О чем говорит повышенный уровень железа крови?
Уровень железа в сыворотке крови считается повышенным при значении выше 30,4 мкмоль/л. Это может быть связано с заболеваниями или передозировкой железосодержащих препаратов. Повышение происходит, когда поступление железа превышает его расход и выведение.
Избыток железа делится на первичный и вторичный. Первичный вызван наследственным заболеванием — гемохроматозом, вторичный — заболеваниями внутренних органов и внешними факторами.
Повышенный уровень железа в крови может наблюдаться при:
- Гемохроматозе. Наследственное заболевание, нарушающее обмен железа и приводящее к его накоплению в органах, что может вызвать цирроз печени, артрит, диабет и другие болезни.
- Анемиях (гемолитической, гипопластической, апластической, сидеробластной и др.). Увеличение уровня железа происходит по разным причинам, в зависимости от типа анемии. Например, при гемолитической анемии разрушаются эритроциты, высвобождая железо, а при сидеробластной — нарушается его утилизация для синтеза гемоглобина.
- Талассемиях. Наследственное заболевание, при котором нарушается синтез гемоглобина, что снижает расход железа.
- Острых отравлениях железом. Возникают при передозировке (до 200 мг), что может произойти из-за бесконтрольного приема препаратов или случайного употребления детьми.
- Заболеваниях печени, селезенки и поджелудочной железы. Патологии этих органов могут нарушать обмен веществ и вызывать гормональные сбои, что приводит к накоплению железа.
- Нарушениях обмена железа. Разные заболевания могут вызывать как снижение, так и повышение уровня железа.
- Чрезмерном поступлении железа. Это может происходить при самолечении препаратами железа или при нормальном поступлении и нарушении обмена.
- Предменструальном периоде. Увеличение уровня железа в этот период считается нормальным; анализ лучше сдавать после менструации.
- Частых переливаниях крови. Регулярные переливания могут приводить к повышению уровня сывороточного железа.
Симптомы повышенного уровня железа в крови:
- тошнота, рвота, изжога, запор или диарея;
- повреждение слизистой кишечника;
- потеря аппетита, снижение массы тела;
- печеночная недостаточность;
- апатия, снижение работоспособности;
- боли и отечность в суставах;
- развитие артрита, атеросклероза, диабета;
- снижение иммунитета;
- гиперпигментация кожи, серо-коричневый оттенок;
- выпадение волос;
- боли в мышцах;
- задержка физического и умственного развития у детей;
- снижение либидо.
Как снизить уровень железа в крови?
Избыточное содержание железа в организме может вызвать заболевания, такие как инфаркт миокарда, печеночная недостаточность, диабет, артрит и рак. В тяжелых случаях это может привести к летальному исходу. Поэтому при подтвержденном повышенном уровне железа в крови необходимо принять меры для его снижения.
Способы снижения уровня железа в крови:
- Использование медикаментов. Для выведения железа применяются гепатопротекторы, препараты цинка и средства, связывающие железо, такие как дефероксамин (десферал) и тетацин кальция.
- Специальная диета. При избытке железа следует исключить из рациона продукты, содержащие этот микроэлемент: мясо, фасоль, сушеные грибы, яблоки, груши, морепродукты. Не рекомендуется принимать витамины, способствующие усвоению железа (группа В, витамин С, фолиевая кислота). Рекомендуется увеличить потребление кофе, чая и продуктов, богатых кальцием, а также препаратов кальция и цинка.
- Регулярное кровопускание. Процедура включает забор около 350 миллилитров крови раз в неделю. Пациент может стать донором крови.
- Гирудотерапия (лечение пиявками). Пиявки, питающиеся кровью, способствуют снижению уровня железа за счет потери гемоглобина.
- Обменное переливание крови. Эта процедура применяется при тяжелых случаях отравления железом и включает забор крови из организма пациента и переливание донорской крови.
Почему гемоглобин низкий при нормальном уровне сывороточного железа?
При некоторых заболеваниях уровень гемоглобина может снижаться, даже если уровень сывороточного железа нормальный или повышенный. Анемия, характеризующаяся низким уровнем гемоглобина, может возникать при достаточном поступлении железа. Низкий гемоглобин негативно сказывается на всех органах, вызывая кислородное голодание клеток и нарушения обмена веществ. Почему при нормальном уровне железа наблюдается недостаточная выработка гемоглобина?
Одной из причин является нехватка витамина В12 и фолиевой кислоты, необходимых для образования эритроцитов.
Основные причины нехватки витамина В12 и фолиевой кислоты:
- Нарушение всасывания. Проблемы с усвоением витаминов могут возникать при атрофии желез дна желудка, заболеваниях кишечника (терминальный илеит, дивертикулез, кишечные свищи, опухоли) и после операций на желудке и кишечнике (гастрэктомия, резекция кишечника).
- Увеличенная потребность. Повышенная потребность в витаминах наблюдается во время беременности, при кишечном дисбактериозе, наличии паразитов, заболеваниях печени (хронический гепатит, цирроз), опухолевых заболеваниях крови и приеме некоторых медикаментов (сульфаниламиды, противосудорожные).
- Недостаток в рационе. Диеты с ограниченным поступлением витаминов из пищи.
Недостаток витамина В12 и фолиевой кислоты может проявляться сонливостью, вялостью, снижением артериального давления, ухудшением состояния волос и ногтей, ярко-красным языком и гортанью, а также болями в области желудка, тошнотой, рвотой и неустойчивым стулом.
Лечение включает внутримышечное введение витамина В12 в дозе 500-1000 мкг ежедневно в течение 10 дней, затем 2-3 раза в месяц в профилактических целях. Фолиевая кислота назначается в дозе 50-60 мг в сутки.
Еще одной причиной анемии при нормальном уровне железа может быть недостаток эритроцитов или неполноценность белка гемоглобина.
Причины недостатка эритроцитов или неполноценности гемоглобина:
- Серповидноклеточная анемия. Это наследственное заболевание связано с нарушением структуры гемоглобина, из-за чего он принимает серпообразную форму. Клинические проявления включают тромбозы сосудов, гемолитическую анемию, бледность, желтушность кожи, спленомегалию (увеличение селезенки), гепатомегалию (увеличение печени), одышку и общую слабость. Серповидноклеточная анемия неизлечима. Симптоматическое лечение во время кризиса включает адекватную гидратацию, переливание эритроцитарной массы и внутривенное введение антибиотиков.
- Разрушение эритроцитов под воздействием химических веществ. Разрушение может происходить под воздействием мышьяка, свинца, нитритов, аминов и ядов. Это приводит к повреждению мембран эритроцитов и высвобождению гемоглобина в плазму, что вызывает распад белков и повреждение почек и печени. Первая помощь включает введение специфических антидотов, например, противозмеиных сывороток.
- Заболевания органов кроветворения. Недостаток эритроцитов может наблюдаться при заболеваниях, таких как рак крови (лимфосаркома, лимфогранулематоз), когда патологические клетки замещают клетки-предшественники эритроцитов.
Какие последствия дефицита железа?
Около 30% мирового населения испытывает нехватку железа, и примерно 20% из них не подозревают об этом. Железо важно для здоровья, так как является ключевым компонентом гемоглобина, который транспортирует кислород от легких ко всем органам. Нехватка железа может привести к железодефицитной анемии, при которой нарушается синтез гемоглобина.
Недостаток кислорода вызывает хроническое кислородное голодание на клеточном уровне, что приводит к изменениям в органах. Железо содержится во многих ферментах и в клетках печени, селезенки, мышц и костного мозга. Его дефицит вызывает слабость, недомогание, головокружение и снижение работоспособности. Также ухудшаются функции органов, снижается выработка ферментов и гормонов, что ослабляет иммунную систему и увеличивает частоту простуд.
На коже дефицит железа проявляется бледностью и сухостью, что может привести к дерматитам и экземам. Пациенты часто страдают от бронхитов, трахеитов и ринитов. В сердечно-сосудистой системе могут возникать боли в области сердца, пониженное артериальное давление и одышка при физической активности.
Недостаток железа также вызывает истончение слизистой оболочки желудочно-кишечного тракта, что может проявляться болями или жжением в языке, изменением вкусовых предпочтений и снижением кислотности желудочного сока, что приводит к образованию эрозий и язв.
Мышечная слабость может вызывать ложные позывы на мочеиспускание и недержание мочи при кашле, смехе или физическом напряжении. У детей хроническая железодефицитная анемия замедляет рост, ухудшает память и внимание, а также вызывает проблемы с обучаемостью и ночное мочеиспускание.
У беременных женщин дефицит железа может привести к преждевременным родам, выкидышам и мертворождениям.
Железо — жизненно важный микроэлемент. Его недостаток или избыток негативно сказывается на органах и тканях, влияя на качество жизни. В некоторых случаях дефицит может привести к необратимым последствиям, а серьезные нарушения уровня железа могут угрожать жизни.
Вопрос-ответ
О чем говорит повышенное железо в сыворотке?
Повышенный уровень железа может быть результатом нарушения функции печени, когда орган не справляется с регуляцией метаболизма железа. Хронический гепатит, алкогольная болезнь печени и цирроз могут сопровождаться избыточным накоплением железа. Передозировка препаратами железа.
Какой уровень сывороточного железа считается критическим?
Считается, что критической в отношении развития дефицита железа является кровопотеря, равная 40-60 мл крови за цикл.
Сколько должно быть железа в сыворотке?
Нормальное значение в крови сывороточного железа для взрослого — 5,83-34,5 мкмоль/л. Гиперферремия — это состояние повышенного значения сывороточного железа (выше 34,5 мкмоль/л).
Советы
СОВЕТ №1
Регулярно проверяйте уровень сывороточного железа в крови, особенно если у вас есть предрасположенность к анемии или другим заболеваниям, связанным с дефицитом железа. Это поможет своевременно выявить проблемы и принять необходимые меры.
СОВЕТ №2
Обратите внимание на свой рацион. Включайте в него продукты, богатые железом, такие как красное мясо, печень, бобовые, орехи и зеленые листовые овощи. Это поможет поддерживать нормальный уровень железа в организме.
СОВЕТ №3
Если у вас наблюдаются симптомы, такие как усталость, слабость или бледность кожи, не откладывайте визит к врачу. Эти признаки могут указывать на низкий уровень железа, и важно получить профессиональную консультацию и, при необходимости, лечение.
СОВЕТ №4
Изучите влияние других витаминов и минералов на усвоение железа. Например, витамин C способствует лучшему усвоению железа из растительных источников, поэтому старайтесь сочетать продукты, богатые железом, с цитрусовыми или другими источниками витамина C.